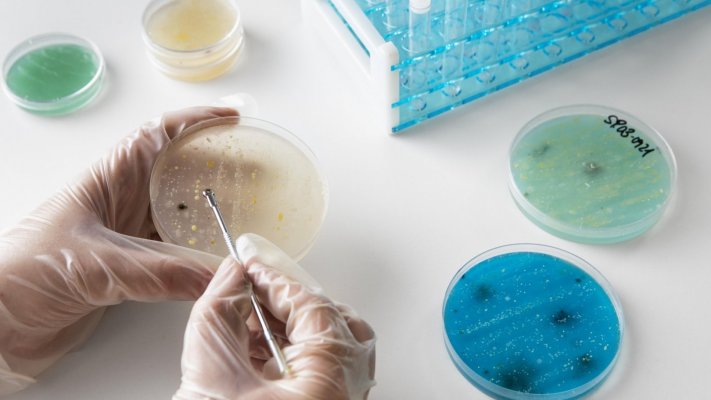

Descobertas moléculas fluorescentes que brilham e permitem ver melhor células humanas
Uma equipa de especialistas de instituições espanholas descobriu moléculas fluorescentes que brilham na água e permitem uma melhor visualização das células humanas.
O desenvolvimento desta nova família de moléculas fluorescentes tem aplicações promissoras no estudo de células vivas e na medicina do futuro, referiu na quinta-feira a Universidade de Málaga em comunicado, sobre o estudo em que participou também o Instituto de Investigação Biomédica de Málaga (IBIMA).
A descoberta foi publicada na Advanced Materials, uma das revistas científicas mais influentes do mundo, que convida apenas grupos de investigação de renome internacional a publicar, noticiou a agência Efe.
De acordo com a publicação, a equipa de investigadores criou uma nova família de moléculas fluorescentes que brilham de forma surpreendente.
É normal que este tipo de moléculas perca parte da sua intensidade ou mude para tons mais baços quando dissolvido em água ou outros meios biológicos.
No entanto, estas novas moléculas fazem exatamente o oposto, emitindo uma fluorescência mais intensa à medida que a sua cor muda para a região azul do espetro de luz.
Este comportamento, que os cientistas descrevem como "contraintuitivo", é fundamental porque significa que os corantes funcionam melhor em meios aquosos, como o interior de uma célula, o que é essencial para aplicações biomédicas.
Por outras palavras, não diminuem a intensidade da luz quando mais necessário, mas mantêm — e até aumentam — o seu brilho em condições reais.
Este avanço faz todo o sentido quando aplicado à biomedicina, pois estes novos corantes permitem que o interior das células seja "fotografado" com grande precisão e sem as danificar, graças a uma técnica chamada microscopia multifotão.
Este método penetra mais profundamente no tecido vivo, obtendo imagens mais nítidas e seguras.
O mais impressionante é a sua capacidade de marcar seletivamente as mitocôndrias, as chamadas "centrais energéticas da célula", responsáveis por fornecer a energia necessária à vida e que desempenham um papel fundamental em doenças como o cancro e as patologias neurodegenerativas, segundo os investigadores.
As experiências demonstraram que as novas moléculas oferecem uma qualidade de imagem comparável à dos corantes fluorescentes, mas com uma vantagem decisiva: são mais fáceis e baratas de produzir.
A descoberta abre caminho para ferramentas de diagnóstico mais acessíveis para o estudo de processos celulares essenciais e, no futuro, para a melhoria da deteção precoce de doenças.
"Estas moléculas não só desafiam uma regra estabelecida na química fluorescente, como também abrem caminho a novas ferramentas para o estudo de doenças em que a função das mitocôndrias é fundamental. É um exemplo do que se consegue quando a química fundamental se une à investigação aplicada em biomedicina", salientaram os professores Ezequiel Pérez-Inestrosa e Juan Casado, da Universidade de Málaga.

ULS Viseu Dão-Lafões implementa sistema digital de atendimento telefónico nas USF

Aplicação para ajudar cegos em tarefas do dia a dia disponível para iphone

Peticionários contra falta de fundamentação para deslocalizar consumo assistido do Porto

Organizações lançam manifesto pelos 20 anos da despenalização da IVG em Portugal

Liga alerta que INEM quer excluir motas de socorro do financiamento aos bombeiros

Venezuela/Sismo: Equipas de socorro da ONU a caminho do país - PR interina

OLEIROS: Campanha de apoio à esterilização de animais de companhia

SERTÃ: Centro de saúde recebe novo equipamento de radiologia

Alerta de "calor extremo" prolongado até sexta-feira em parte do Reino Unido

Universidade de Lisboa aprova curso de Enfermagem para Torres Vedras

Venezuela/Sismo: ONU apela à colaboração internacional
